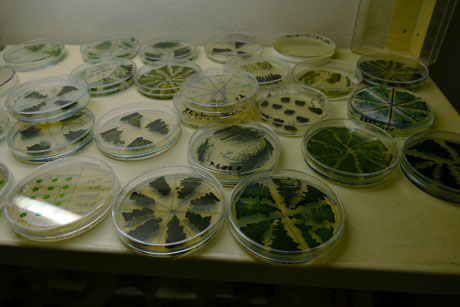
160713_algatech5

Tajemství řas a sinic
13. 07. 2016

Mikroskopické organismy, které většinou zůstávají na okraji zájmu laiků, mohou biology dovést k mnoha informacím o nejzákladnějších pochodech v živých buňkách, ale také nabídnout nové léčebné látky i zdroje paliv. Řeč je o řasách a sinicích.
Procházím bránou a velké panely mi hned připomínají, že sinice neboli cyanobakterie jsou jednoduché a starobylé organismy – na Zemi se vyskytují už neuvěřitelné tři miliardy let; jde o prokaryotické organismy s bezjadernou buňkou schopné fotosyntézy rostlinného typu, oproti řasám jsou modrozelené. Neodborníci si jich všimnou asi pouze v létě, když se přemnoží a tvoří na vodních plochách nevzhledné zelené povlaky známé jako vodní květy, které kvůli uvolňovaným toxickým látkám znemožňují koupání. Sinice však produkují daleko víc složitých organických látek, škálu sekundárních metabolitů s různým působením – mohou být nejen nebezpečné, ale i zdraví prospěšné. Mikrobiologové se je proto snaží poznat a řízeně kultivovat, aby z nich dokázali získat třeba léčebné látky s antivirovými účinky, cytostatika pro boj proti nádorům nebo biologické pesticidy. Cenné látky pro farmakologii, potravní doplňky, biotechnologie, biopaliva, krmiva a další účely poskytují i řasy. Ty jsou výrazně mladší než sinice, jsou staré „jen“ asi 1,5 mld. let, mají buněčné jádro ohraničené membránou, jedná se tedy o eukaryotické organismy, a jsou asi pětkrát až 10krát větší než sinice. Sinic a řas bylo už sice popsáno několik desítek tisíc, mnoho druhů však ještě zatím nebylo objeveno. Poznat nejen je samé či látky, které produkují, ale jejich pomocí popsat i základní životní pochody společných pro mnoho dalších organismů na Zemi, včetně fotosyntézy či zvláštního buněčného dělení zelených řas, je cílem třeboňských badatelů.
Ujímá se mě vedoucí centra Algatech prof. Ondřej Prášil a vysvětluje: „Kvalitní aplikovaný výzkum musí být vždy v těsném spojení s výzkumem základním. Takže součástí rekonstruovaných laboratoří je i nové vybavení pro molekulární a buněčnou biologii.“
V přírodě je podle Ondřeje Prášila minimálně 70 tisíc druhů řas a jsou vývojově velmi rozmanité: „Řasy v sobě tudíž mají ohromný potenciál. Na rozdíl od vyšších rostlin rostou velice rychle, jejich buňky se dělí minimálně jednou za den, takže pokud potřebujeme získat velké množství biomasy, právě řasy by mohly být a jsou ideálním zdrojem.“
Výzkumy na tomto poli jsou doménou Laboratoře řasové biotechnologie centra Algatech, která se zabývá technologiemi řasové produkce, jejich optimalizací a zpracováním produktů i různým využitím řasové biomasy. K vysoce efektivní produkci řas slouží už několik desetiletí venkovní kultivační jednotky: vypadají jako obří plochá kaskádovitá skleněná akvária, po jejichž povrchu stéká a bují řasová biomasa. Jde o druhou generaci tohoto zařízení dokončenou v roce 1989 – první se datuje už do šedesátých let minulého století. Pěstují se v nich zhruba od května do října zelené sladkovodní řasy Chlorella bohaté na bílkoviny, konkrétně kmen vyselektovaný v našem klimatickém pásmu, takže velmi dobře rostou. Venkovní kultivační jednotky doplňují i fotobioreaktory využívající umělých zdrojů světla. Jak mi dále objasňuje dr. Jiří Kopecký, uvnitř, v nové technologické hale vybudované v rámci projektu Algatech se kultivují opět řasy Chlorella: „Avšak jde o úplně jiný kmen, který je schopen růst bez světla na organickém substrátu – v tomto případě používá jako zdroj energie glukózu. Pro nás to má ohromnou výhodu, protože nejsme závislí na počasí a můžeme celou technologii provozovat po celý rok.“
Dozvídám se, že se v Třeboni řízeně pěstují též řasy Chlorella obohacené o stopové prvky, jichž je v lidské stravě nebo v krmivu pro zvířata nedostatek, například jod, selen, chrom, které jsou v řasách biologicky vázané, a tudíž lépe využitelné než v anorganických zdrojích. I proto je Chlorella schválená jako potravní doplněk zdravé výživy, takže se pěstuje, suší a prodává jako zdroj hodnotných látek pro výživu a zdravotnictví. Badatelé v Mikrobiologickém ústavu AV ČR v Třeboni také v řasách a sinicích cíleně vyhledávají nové biologicky aktivní látky ovlivňující biologické chování savčích buněk, jež by bylo možné jednou využít ve farmakologii a biomedicíně. Pro identifikaci těchto dosud neznámých látek využívají spojení kapalinové chromatografie a hmotnostního spektrometru.
„V posledních letech jsme se zaměřili specificky na látky, které inhibují dělení nádorových buněk či selektivně indukují apoptózu neboli buněčnou smrt, ,sebevraždu‘ těchto nádorových buněk,“ dodává dr. Kopecký a vysvětluje dál, že řasy izolované z přírody se napěstují, filtrací nebo centrifugací se jejich buňky oddělí od kultivačního média, pak se z nich extrahují všechny dostupné látky a podrobí primárnímu testování na příslušnou biologickou aktivitu – například právě na zmíněnou selektivní cytotoxicitu. „Každý extrakt obsahuje desítky v první fázi pro nás zcela neznámých látek. Pokud najdeme na surovém extraktu nějakou aktivitu, pak se ho snažíme frakcionovat na jednotlivé komponenty a tyto složky opět podrobíme testování na buněčných liniích. Tímto jednoduchým způsobem dokážeme zjistit, která látka vykazuje patřičnou biologickou aktivitu.“

Mikroskopické snímky (epifluorescenční, SEM a TEM) nově nalezené bakterie Gemmatimo-nadetes
Mimořádný úspěch zaznamenali i v Laboratoři anoxygenních fototrofů centra Algatech, která se zabývá základním výzkumem evolučně velmi staré skupiny prokaryot obsahující fotosyntetický aparát tvořený bakteriochlorofylem. Pomocí speciálního infračerveného zobrazovacího zařízení vyvinutého v Mikrobiologickém ústavu AV ČR izolovali z jezera Tian-er-hu v poušti Gobi zcela novou skupinu fototrofních organismů. Za posledních 100 let byly přitom popsány pouze tři nové skupiny fototrofních bakterií. Jak badatelé uvádějí na internetových stránkách http://www.alga.cz/, fotosyntetický aparát nového druhu je tvořen bakteriálními reakčními centry obsahujícími světlosběrná barviva bakteriochlorofyl a spirilloxanthin. Fylogenetická analýza naznačuje, že schopnost využívat energii světla získal tento organismus díky horizontálnímu přenosu genů z purpurových bakterií (Proteobacteria). Popsaný druh tak představuje první příklad, kdy byla mezi fylogeneticky velmi vzdálenými skupinami přenesena kompletní sada přibližně 30 genů nutná pro fungování bakteriální fotosyntézy. Dosud byly popsány pouze přenosy jednotlivých genů.
Mikrobiologové nový organismus detailně charakterizovali, sekvenovali jeho genom a studii publikovali v časopise PNAS (Proceedings of the National Academy of Sciences of the United States of America). Vedoucí laboratoře dr. Michal Koblížek zdůrazňuje, že na výzkumu fotosyntetických bakterií je zajímá především jejich různorodost. „Schopnost využívat energii světla byla pro přírodu velmi důležitá. Teprve když živé organismy začaly využívat nevyčerpatelnou energii Slunce, mohly se rozvinout v celé dnešní bohatosti a šíři. První fototrofní organismy se vyvinuly před 3,5 mld. let. A nás při výzkumu zajímalo, zda jsou objeveny všechny skupiny organismů využívající energii světla, nebo jestli ještě můžeme najít něco nového.“
Říše mikroorganismů je stále ještě málo probádaná, takže by se laikovi zdálo, že objevit nový organismus není zase tak převratná událost – proč vás právě tento organismus upoutal, že jste ho začali podrobněji zkoumat?
Představuje nové bakteriální fylum – pro srovnání: bakteriálních fyl, tedy skupin, které využívají energii světla, bylo zatím popsáno pouze šest a teď jsme popsali sedmé, takže je to poměrně významný objev, jaký se nepodaří každý den. Uvedený organismus nebyl jediný, který jsme získali, izolovali jsme jich víc – a věříme, že se nám podaří popsat ještě něco zajímavého.
Jakým způsobem se hledají nové organismy?
Když jsme si stanovili plán hledat nové fotosyntetické organismy, sestrojili jsme si speciální zobrazovací zařízení, s jehož pomocí jsme mohli velmi rychle identifikovat fototrofní organismy. Zařízení využívá toho, že každý fotosyntetický organismus v sobě obsahuje světlosběrná barviva, která je možné zobrazit pomocí speciální infračervené kamery. Zmíněné zařízení je unikátní, je zatím pouze v naší laboratoři, ale máme zájemce o jeho postavení i z jiných zemí – včetně Japonska, USA a Číny. Jedním z cílů centra Algatech je také podpořit aplikovaný výzkum.
Říkal jste, že zatím bylo popsáno šest hlavních skupin bakterií využívajících fotosyntézu. Vy jste popsali sedmou, je pravděpodobné, že jich zatím ještě většina nebyla odhalena?
Celkem je bakteriálních fyl formálně popsáno přes 30, z nichž sedm obsahuje fotosyntézu. Předpokládáme, že vzhledem k tomu, jak starý proces fotosyntéza je, mohlo by se skupin najít i víc. Napovídá tomu i fakt, že fotosyntéza v organismu, v němž jsme ji popsali, byla přenesena horizontálně, takže geny zodpovědné za fotosyntézu byly získány z jiných organismů. Pokud je tedy možné přenášet fotosyntetické geny relativně daleko, mezi různými bakteriálními skupinami, potom bychom jich mohli v budoucnu najít ještě víc.
Má oněch sedm skupin bakterií společného ještě něco jiného, nebo je fotosyntéza to jediné, co je spojuje?
Společného moc nemají, jsou to ale všechno bakterie – zatím jsme nenašli fotosyntézu ve skupině Archea. U Eukaryot je fotosyntéza vlastně zprostředkovaně ve formě chloroplastů, což je v podstatě endosymbiotická sinice. Zdá se proto, že se fotosyntéza vyvinula pouze ve skupině Bakterií. Ty jsou při-tom poměrně vývojově vzdálené a žijí v různých prostředích – některé skupiny organismů jsou v přírodě velmi běžné, například sinice – ty zná skoro každý. Jiné jsou poměrně vzácné – žijí třeba v půdě. Jeden z nedávno popsaných fototrofních organismů (představuje šestou skupinu) byl objeven v roce 2007 v horkých pramenech v Yellowstoneském národním parku: žije tam za velmi neobvyklých podmínek, v kyselé vodě a za teploty přes 50 °C, takže tato šestá skupina je poměrně neobvyklá. Naopak náš organismus zřejmě tak neobvyklý není, je rozšířen v půdě, ve sladkých vodách a sedimentech.
Z vašich slov plyne, že fotosyntéza je charakteristická pro skupiny navzájem i velmi odlišné. Znamená to, že se v evoluci vyvinula několikrát? Proč se vlastně přenáší v těchto tak odlišných skupinách?
Schopnost využívat energii světla se podle všeho vyvinula několikrát. Jednak máme fotosyntézu založenou na pigmentech chlorofylu nebo jejich analozích, které se nazývají bakteriochlorofyl, jednak existuje ještě další skupina organismů, které zachycují světlo pomocí rodopsinu. Bakteriální rodopsiny jsou podobné bílkovinám rodopsinu, které umožňují vidění v lidském oku. Nejedná se o plnou fotosyntézu, pomocí zmíněných rodopsinových molekul bakterie pouze získávají ATP, nemohou fixovat uhlík.

Umělecký fylogenetický strom bakterií s vyznačením hlavních skupin (fyl), které obsahují fotosyntetické organismy.
Hlouběji do základních procesů v živých organismech se snaží pronikat i Laboratoř buněčných cyklů řascentra Algatech v Třeboni pod vedením dr. Kateřiny Bišové. Studuje konkrétně molekulární mechanismy regulace specifického buněčného cyklu řas, pro něž je typické násobné dělení: mateřská buňka se nemusí rozdělit pouze na dvě dceřiné, ale prochází nejprve dlouhou růstovou fází, během níž několikrát zdvojnásobí svůj objem. Posléze dojde k několika replikacím DNA a k jaderným a buněčným dělením, kdy se původní buňka běžně dělí na čtyři, osm i více buněk dceřiných. Kromě molekulárních mechanismů vzájemné regulace mezi velikostí buňky a dělením a role cyklin dependentních kináz v komplexu s cykliny v průběhu buněčného cyklu je cílem třeboňských vědců poznat i funkci konkrétních kináz jak v regulaci běžného buněčného cyklu, tak pro jeho zastavení po poškození DNA – a tedy také jak buněčné dělení případně zablokovat. Kateřina Bišová konstatuje, že buněčný cyklus řas v mnohém připomíná embryonální dělení: „Budeme-li studovat řasy, můžeme mj. pochopit, jak se vyvíjejí živočišná embrya: jak buněčný cyklus, tak rané fáze růstu a vývoje živočišného embrya jsou totiž regulovány podobnými principy, jakými jsou řízeny řasy. Druhý zajímavý moment představuje fakt, že řasy – stejně jako ostatní rostliny – jsou v přírodě vystaveny velkému množství látek poškozujících DNA. Proto si vyvinuly mechanismy, které jim umožňují se proti tomu bránit. Jednobuněčné řasy se studují poměrně snadno a mohou se stát modelem pro výzkum toho, jaké mechanismy chrání buňky před poškozením DNA.“ Získaných poznatků by se podle dr. K. Bišové mohlo jednou využít pro léčbu různých onemocnění, včetně rakoviny.

Fotografie z fluorescenčního mikroskopu synchronní kultury řasy Chlamydomonas reinhardtii, u které jsou buněčná jádra obarvena pomocí fluorescenčního barviva Sybr Green a září žlutozeleně, chloroplasty září červeně díky autofluorescenci.
V historické budově Opatovického mlýna sídlí i Laboratoř fotosyntézy, jež se orientuje na molekulární ekofyziologii a biochemii fotosyntézy řas a sinic. Mohlo by se zdát, že tak základní proces na Zemi už je vědcům podrobně znám – překvapivě tomu ale tak není: vědci se stále snaží proniknout až k samé podstatě procesu, jakým řasy získávají energii ze slunce, či jak usměrňují fotosyntetický proces v průběhu dne nebo za určitých stresových podmínek, což dokládají i slova prof. O. Prášila: „Fotosyntéza jako taková, její základní principy už samozřejmě poznány jsou. Stále však neznáme důležité podrobnosti týkající se způsobu, jímž se fotosyntéza reguluje, jak je zapojena do celkového metabolismu buňky. Stále také hledáme, jak souvisí s druhovou rozmanitostí řas, protože řasy jsou schopné růst v téměř jakémkoli prostředí.“
Vcházím doLaboratoře fotosyntézy, kterou vede prof. Josef Komenda, a dozvídám se, že jeho skupina je poměrně velká, má řadu oddělení, každé s trochu jiným zaměřením, i když je spojuje právě fotosyntéza. Pracují s několika typy modelových sinic, u nichž lze dobře uplatnit moderní biochemické a molekulárně-biologické přístupy. Josef Komenda a jeho kolegové se věnují především studiu mechanismů tvorby a poškození složitého bílkovinného komplexu přítomného v buňkách rostlin, řas a sinic zvaného fotosystém II i regulaci a dynamice fotosyntézy ve fyto-planktonu. Už se jim podařilo na tomto poli získat řadu zásadních poznatků. Mimo jiné společně s kolegy z britských univerzit popsali první kroky procesu skládání fotosystému II, jehož funkce je pro fotosyntézu zásadní. Objasnili mechanismus zabudovávání molekul chlorofylu do základních stavebních bílkovin a sestavování funkčního jádra fotosystému.
Jinými slovy – jak dokládají práce publikované už v roce 2014 v prestižním časopise Plant Cell – jste zjistili, jak buňky postupně skládají jednotlivé složky fotosystému II do jeho konečné, komplikované struktury. Využili jste k výzkumu opět sinic – proč a co vás zajímalo především?
Položili jsme si otázku, jaké proteiny se účastní procesu vzniku fotosystémů, což jsou komplexy bílkovin vážící pigmenty, jako je chlorofyl a karotenoidy, a představují vlastně základní prvek fotosyntézy: ony pohlcují sluneční světlo a pak ho transformují na chemickou energii. Způsob, jímž dané komplexy vznikají, fakticky není znám. Samozřejmě se předpokládalo, že pro správný průběh tohoto procesu je potřebná účast řady dalších pomocných bílkovin neboli proteinů, které ale nejsou součástí konečného, plně funkčního komplexu. My jsme některé z těchto pomocných bílkovin ve fotosystémech našli, ale neznali jsme vůbec jejich funkce. Proto jsme se domluvili s kolegy – molekulárními biology, aby gen kódující danou bílkovinu inaktivovali, a následně jsme zjišťovali důsledky tohoto kroku. Ukázalo se, že tvorba jednoho komplexu, speciálně fotosystému II, se výrazně zbrzdí. U rostlin, s nimiž pracuje jiná skupina, se zjistilo, že bez dotyčného proteinu se dokonce daný fotosystém vůbec nevytvoří. Pak kolegové připravili tento protein s tzv. kotvou – a my jsme zjišťovali, co se na ukotvenou bílkovinu naváže. Výsledkem bylo, že jsme spolu se známými složkami fotosystému II nalezli i proteiny, které vážou karotenoidy – a vlastně tedy plní ochrannou funkci v době, kdy onen komplex vzniká: jelikož už má na sebe navázaný chlorofyl, je velmi citlivý na fotooxidaci a je potřeba ho neustále chránit, protože sinice je v té době na světle a neustále pohlcuje energii, která by měla být zužitkována. Pokud ovšem fotosystém není dotvořen, energie využita být nemůže a v důsledku toho může vznikat celá řada toxických, reaktivních forem kyslíku, které potom mohou nově vytvářený komplex nevratně poškodit.
Otevřením centra Algatech v roce 2014 jste získali nové prostory i přístrojové vybavení. V čem vám to pomůže?
Mohli jsme v první řadě zefektivnit naši práci. Nové přístroje, které jsme dříve neměli, slouží k tomu, abychom některé ze zmiňovaných postupů a metod mohli vůbec provádět nebo nově zavést. Velmi často se například využívá značení pomocí radioizotopů, jejichž prostřednictvím můžeme sledovat, jak rychle jsou které bílkoviny syntetizovány. K tomuto účelu jsme díky centru mohli zakoupit nové přístroje schopné vyhodnocovat zabudování radioaktivních izotopů. To je jen jeden z případů, kde nám centrum Algatech a získané přístroje výrazně pomohly.
(Nejnověji prof. J. Komenda se svými kolegy publikoval v prosincovém čísle časopisu Nature Plants další z objevů týkajících se fotosystému II – tentokrát jde o výrazně nový pohled na mechanismus jeho opravy – viz následující článek Další úspěch třeboňských vědců při poznávání tajů fotosyntézy.)
Molekulární biolog dr. Martin Tichý rovněž používá k základnímu výzkumu fotosyntézy a souvisejících procesů jako modelový organismus sinice. Na otázku proč odpovídá, že podle dnes už potvrzené a vše-obecně přijímané endosymbiotické teorie jsou chloroplasty vyšších rostlin původem ve skutečnosti autonomní organismy, s největší pravděpodobností právě sinice, které byly pohlceny jinou buňkou.
Znamená to, že sinice jsou vývojově daleko starší?
Samozřejmě – a jsou to tudíž organismy, v nichž byla, „vynalezena“ fotosyntéza jako taková, jak ji známe u vyšších rostlin. Pro nás jsou z toho důvodu sinice modelovým organismem a velkou část výsledků, které na nich získáme, jsme potom schopni víceméně přímo aplikovat na vyšší rostliny, jejichž studium je z principiálních důvodů komplikovanější. Naším základním přístupem je inaktivace genů; studujeme například fotosystémy v tylakoidních membránách sinic a vyšších rostlin. Fotosyntéza probíhá ve fotosystémech I a II, což jsou ohromné membránové komplexy tvořené desítkami proteinů – a nás zajímá funkce každého z nich. Našemu přístupu se říká reverzní genetika na rozdíl od genetiky klasické. V klasické genetice nejdříve získáváte nějaké mutanty, jež se pak snažíte charakterizovat. Princip reverzní genetiky spočívá v tom, že systematicky vypínáte – inaktivujete – jednotlivé geny a zjišťujete, k jaké změně došlo ve fenotypu příslušného organismu, to znamená v našem případě především ve fotosyntéze. Každý gen kóduje určitý protein, když tedy inaktivujete určitý gen, víte, že jím kódovaný protein bude chybět. Následně můžete zjišťovat, jakým způsobem se v důsledku toho změní struktura nebo funkce příslušného fotosystému.
Zmíněný přístup ovšem znamená, že musíte mít zkoumané organismy velmi dobře zmapované po genetické stránce, znát přesně jednotlivé geny?
V tom je další výhoda sinic, že totiž mají relativně malý genom; ve srovnání například s řasami asi desetinový. Sinice jsou v podstatě bakterie, takže i velikost jejich genomu je srovnatelná s dalšími bakteriemi. Sinice kódují řádově dva až pět tisíc proteinů. Celý genom těchto organismů je tudíž sekvenován.

Model selektivní degradace bílkovin D1 a D2 v komplexu PSII. Meziprodukty skládání komplexu PSII (komplexy D1-D2, CP47-D1-D2 a monomerní PSII) jsou znázorněny z pohledu kolmého k rovině membrány. Membránové šroubovice bílkoviny D1 jsou znázorněny červeně, D2 oranžově, CP47 zeleně, CP43 růžově a malé podjednotky modře. Bílkoviny D1 a D2 jsou přístupné proteáze FtsH v nepřítomnosti anténních bílkovin CP43 a CP47 i ve tmě bez poškození komplexů. V případě poškození světlem pravděpodobně dochází ke konformační změně, která vede ke změně vazby antény CP43 a umožní tak přístup protézy k poškozené bílkovině D1.
Geny tedy znáte – jakým způsobem se ale dá gen vypnout?
U sinic je výhodou, že inaktivace jejich genů je velice přímočará a jednoduchá. Mimo buňku připravím DNA mutovaného genu: původní gen z větší části nahradím jiným genem, který způsobuje rezistenci na určité antibiotikum. Uvedený konstrukt pak dostanu procesem zvaným transformace do buňky sinice, která díky vloženému změněnému genu získá odolnost na dané antibiotikum. Když následně sinice umístím do média obsahujícího příslušné antibiotikum, ty se zabudovaným mutovaným genem v něm budou schopny růst – a já tak dokážu určit, které z nich byly transformovány. K transformaci dojde totiž řádově řekněme v jedné buňce z tisíce.
Nakonec vám tedy v daném médiu zbydou pouze buňky odolné vůči danému antibiotiku právě díky genu, který jste do nich vložili – a vy v tom případě máte jistotu, že neobsahují původní gen, který jste odstranili, respektive zaměnili, a jehož vlastnosti vás vlastně zajímaly? Cílem celé procedury je pak sledovat, v čem jsou sinice bez onoho původního genu jiné – ve vašem případě půjde především o změny ve fotosyntéze?
Přesně tak. Můžeme pozorovat celou škálu různých efektů. Některé geny jsou pro organismus nepostradatelné, čili pokud takový gen inaktivuji, sinice nebude například schopná provádět fotosyntézu. Aby rostla, bude muset mít médium obsahující např. glukózu, nebude schopná růst na minerálním médiu, budeme jí muset dodávat nějaký zdroj uhlíku. Nebo může dojít jen k mírné změně ve fyziologii fotosyntézy, kdy se bude tvořit méně fotosyntetických komplexů nebo fotosystémy budou fungovat hůř. Máme zde v ústavu skupinu biofyziků, kteří jsou schopni tyto detekce provádět a změny poměrně jednoduše měřit.
Jaký mají všechny zmíněné procedury konečný cíl? Co chcete nakonec v souvislosti s fotosystémy I a II vyvodit z postupného vypínání jednoho genu po druhém?
Jak už jsme si řekli, jedná se o poměrně složité proteinové komplexy, které je nutno nějakým způsobem sestavovat nebo i opravovat. Tudíž my pomocí zmíněných postupů zjišťujeme, jakým způsobem vlastně k sestavování nebo opravování oněch komplexů dochází. Naším výsledkem a výstupem je poznání, jak příslušný systém funguje, jak se sestavuje a jakým způsobem se může opravovat.
Mají vámi získané poznatky širší platnost?
To, co vyzkoumáme na sinicích, je pak samozřejmě obecně platné i pro vyšší rostliny, protože sledované fotosystémy jako takové fungují u sinic a u chloroplastů vyšších rostlin velice podobně. Přesahuje to samozřejmě do určité míry i rámec fotosyntézy, jelikož funkce a skládání membránových proteinů a membránoproteinových komplexů je daleko obecnější jev, který se studuje poměrně obtížně.
„Jedním z důležitých kroků při tomto výzkumu je vyhodnotit fluiditu membrány a určit její spojitost s funkcí jednotlivých bílkovin,“ doplňuje dr. Radek Kaňa z Laboratoře fotosyntézy centra Algatech.
Kultivace kmenů modelové sinice Synechocystis PCC 6803 v tekutém médiu na agarových plotnách a třepačce (foto viz níže).
Vaše skupina se zaměřuje na dynamiku membrán a komplexů – jak konkrétně své výzkumy provádíte?
Používáme většinou konfokální mikroskop – využíváme buď autofluorescenci daných bílkovin, nebo je případně značíme fluorescenčními proteiny a následně můžeme sledovat, jakým způsobem se pohybují v membráně v důsledku různých změn, fyziologických adaptací a podobně. Konkrétně se většinou zabýváme otázkou, jak je regulována aktivita fotosyntézy, například jak je absorbováno světlo za vysoké ozářenosti a jak se příslušné bílkoviny chrání proti zvýšené ozářenosti. Posléze tato měření provádíme za různých podmínek a snažíme se z daných výsledků, z daných fotografií z konfokálního mikroskopu vyhodnotit, jakým způsobem zkoumaný pohyb probíhá, jak spolu jednotlivé proteiny interagují, jak se ovlivňují navzájem.
Plyne z toho, že pokud na bílkoviny neboli proteiny dopadá příliš mnoho světla, mohly by podlehnout určitému rozkladu – a vy zjišťujete, jaké obranné mechanismy mají, aby k tomu nedošlo?
Přesně tak. Existuje mechanismus tzv. nefotochemického zhášení, což je právě onen obranný mechanismus, jenž se stimuluje za zvýšené ozářenosti, kdy bílkoviny dokážou změnit svou strukturu a následně absorbované světlo disipovat ve formě tepla.
To znamená, že když je světla příliš mnoho, příslušná bílkovina se nějak změní, obmění kupříkladu svůj tvar, aby na její povrch dopadalo záření co nejméně?
Přesný mechanismus není zatím zcela znám. Zatím víme, že v bílkovinách dochází ke strukturálním změnám, při nichž se mění interakce pigmentů absorbujících světlo. Zvyšuje se tím pravděpodobnost, že se absorbované světlo posléze disipuje ve formě tepla a netvoří se volné radikály, které by mohly danou bílkovinu zničit.
Sledujete tyto jevy v reálném čase v konfokálním mikroskopu, nebo staticky, po jednotlivých fázích určujete, jak daná bílkovina vypadá?
Jsou dva přístupy. Jeden se uplatňuje spíše na úrovni jednotlivých buněk, kdy se v konfokálním mikroskopu dá pozorovat, jak se studované proteiny pohybují. Druhým přístupem, který je spíš na úrovni suspenze, sledujeme přeměnu absorbovaného světla na teplo na základě zmenšení nebo zvýšení fluorescence. Stále však není úplně zřejmé, jak celý proces probíhá na molekulární úrovni.

Zatím se jedná o základní výzkum, o poznávání principů fungování fotosyntézy, způsobů její regulace za zvýšené ozářenosti apod. Jaké hlavní problémy musíte překonávat při tomto typu výzkumu?
Asi nejzákladnější je definovat prvotní otázku, kterou se budeme snažit zodpovědět. Když zkoumáme daný protein, musíme najít metodu, jakým způsobem ho lze sledovat. Například v případě využití konfokálního mikroskopu to znamená, že jedná-li se o autofluorescenční protein, máme zjednodušenou cestu, nemusíme používat žádné fluorescenční značení; v případě, že chceme sledovat kupříkladu specifické, nefluoreskující proteiny v tylakoidní membráně, musíme spolupracovat s kolegy – molekulárními biology, kteří nám dokážou tyto proteiny označit fluorescenčními značkami – a my je pak můžeme pozorovat v konfokálním mikroskopu.
Nakolik se poznatky, které získáváte, vztahují pouze na sinice a nakolik na všechny fotosyntetické organismy?
Zajímavé je, že mezi fotosyntetickými mikroorganismy je velká variabilita a my usilujeme o porovnávání různých organismů. Snažíme se výzkum mobility proteinů započít na sinicích, jejichž struktura je velmi jednoduchá, a chtěli bychom ho do budoucna rozšířit i na fotosyntetické řasy, které mají poněkud jinou strukturu, jiný obsah proteinů a jiným způsobem jsou regulovány například za už zmiňované zvýšené ozářenosti. I ve výzkumu fotoprotektivních mechanismů se pokoušíme zároveň rozlišit mezidruhovou variabilitu. Proto se zabýváme různými druhy řas, a to většinou specifickými a evolučně významnými, které jsou charakteristické i svým obsahem proteinů. Na základě tohoto přístupu se snažíme najít obecné mechanismy fotoprotekce pro všechny fototrofní mikroorganismy.
Loučím se s třeboňským pracovištěm Mikrobiologického ústavu AV ČR – a v hlavě mi doznívá tolik zajímavých rozhovorů, poznatků a dojmů, že jdu tentokrát po hrázi Opatovického rybníka téměř automaticky a jeho krásu vnímám jen okrajově.
JANA OLIVOVÁ,
Akademický bulletin
Přečtěte si také
- Vědecká rada na návštěvě v Dolních Břežanech
- Akademický sněm uvítal navýšení rozpočtu. „Je to pozitivní zpráva,“ řekla předsedkyně
- Odborníci hovořili o potenciálu a rizicích genetických modifikací
- ČR hostila 68. plenární zasedání ESFRI
- Potřebujeme ucelenou strategii pro boj se suchem, shodují se čeští odborníci
- Bez omezení benzinové a naftové dopravy nelze splnit cíle Pařížské dohody
- Kosti dokážou to, co kůže a krev. Unikátní výzkum publikoval časopis Nature
- Do Fyziologického ústavu putuje ocenění HR Excellence in Research Award
- Nová databáze DNA představuje vzorky ze starodávných lidských populací
- AV ČR vydala stanovisko k evropskému rámcovému programu Horizon Europe